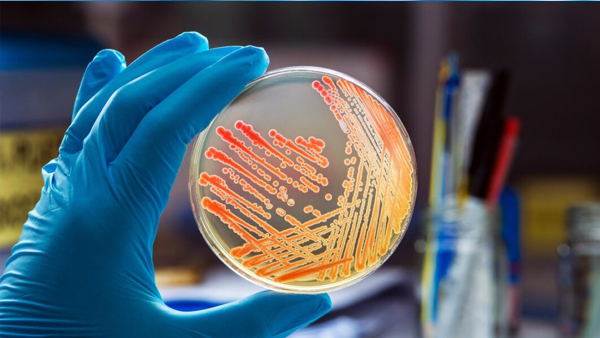

Laboratories
The College has well-furnished class rooms and fully equipped Laboratories with all facilities fulfilling the norms of the Government of Tamilnadu and the Bharathidasan University in order to impart excellent practical knowledge to the students of this College. The Laboratory facilities include.

Computer Lab

Chemistry Lab

Nutrition & Dietetics Lab

Biochemistry Lab
Microbilogy Lab

Biotechnology Lab

Physics Lab

Training Kitchen

Training Restaurant

Model Bed-room

Dyeing Lab

Designing / Tailoring Lab
| S.No. | Lab Name | Link |
| 1 | Computer Lab | View |
| 2 | Chemistry Lab | View |
| 3 | Nutrition and Dietetics Lab | View |
| 4 | Physics Lab | View |
| 5 | Visual Communication Lab | View |
| 6 | Information Technology Lab | View |
| 7 | Fashion Technology Lab | View |
| 8 | Bio-Technology Lab | View |
| 9 | Computer Application Lab | View |
| 10 | Food Production Lab | View |
| 11 | FP Lab (Quality Training Kitchen) | View |
| 12 | FP Lab (Advanced Training Kitchen) | View |
| 13 | FP Lab (Basic Training Kitchen) | View |
| 14 | FP Lab (Bakery Lab) | View |
| 15 | F&B Service Lab | View |
| 16 | Front Office Lab | View |
| 17 | House Keeping Lab | View |



